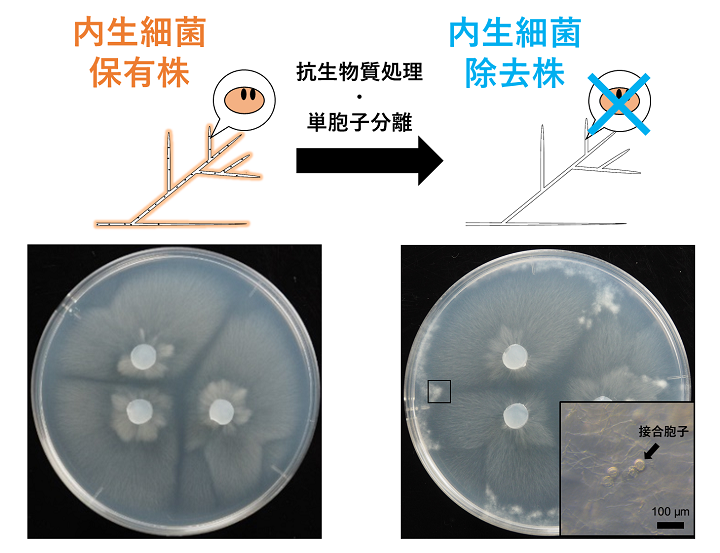

生物・環境
菌類内生細菌が宿主菌類の有性生殖を阻害する例を世界で初めて確認 菌類と内生細菌の共生関係の解明に一石
東京農工大学大学院 連合農学研究科(配置大学:茨城大学)の高島勇介(当時[現 筑波大学山岳科学センター菅平高原実験所 日本学術振興会特別研究員PD])、茨城大学の成澤才彦教授、太田寛行教授(当時[現 茨城大学長])、西澤智康准教授、筑波大学の出川洋介准教授らの研究グループは、菌類の細胞内に生息する「菌類内生細菌」が宿主菌類の有性生殖を阻害する例を初めて発見しました。
菌類のさまざまな形質は菌類単独の性質によってのみ生じるのではなく、実際には内生細菌が介在することで成立しているという可能性が、近年示されています。研究グループでは、菌類内生細菌を除去した株を安定的に作出し、この除去株と内生細菌保有株の有性生殖をそれぞれ観察した結果、菌類内生細菌の存在によって宿主菌類の有性生殖が阻害されることが明らかになりました。この結果は、菌類内生細菌が宿主菌類にとって有益な存在であるという従来の認識に一石を投じるものです。

(図 菌類内生細菌保有株(左)と除去株(右)のコロニー。菌類内生細菌除去株では培地内に菌糸塊が生じ、その中で有性胞子(接合胞子)が形成される(右下黒枠内)。)
菌類のさまざまな形質は菌類単独の性質によってのみ生じるのではなく、実際には内生細菌が介在することで成立しているという可能性が、近年示されています。研究グループでは、菌類内生細菌を除去した株を安定的に作出し、この除去株と内生細菌保有株の有性生殖をそれぞれ観察した結果、菌類内生細菌の存在によって宿主菌類の有性生殖が阻害されることが明らかになりました。この結果は、菌類内生細菌が宿主菌類にとって有益な存在であるという従来の認識に一石を投じるものです。
(図 菌類内生細菌保有株(左)と除去株(右)のコロニー。菌類内生細菌除去株では培地内に菌糸塊が生じ、その中で有性胞子(接合胞子)が形成される(右下黒枠内)。)
